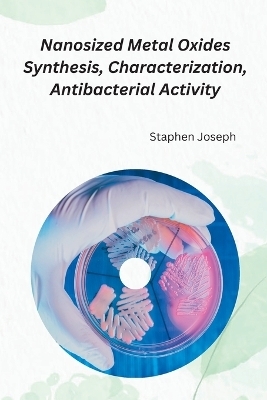
Nanosized Metal Oxides Synthesis, Characterization, Antibacterial Activity

Building and Refining a Collection
Buch | Hardcover
2023
|
The Crowood Press Ltd
ISBN: 9780719842733
CHF 55,90 (inkl. MwSt)
- Versand in
10-20 Tagen